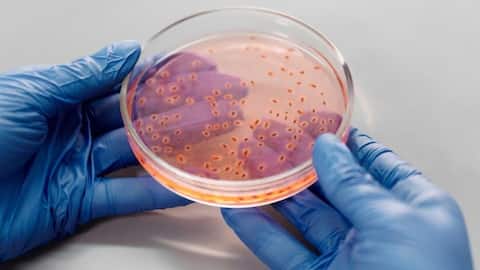

Peran Menarik Bakteri dalam Energi Terbarukan
Apa ceritanya
Bakteri memiliki peran penting dalam menciptakan energi terbarukan. Mereka dapat mengubah bahan organik menjadi sumber energi yang lebih bersih dan berkelanjutan. Dengan memanfaatkan kemampuan alami bakteri, kita dapat mengurangi ketergantungan pada bahan bakar fosil dan mendukung lingkungan yang lebih sehat. Artikel ini akan membahas bagaimana bakteri berkontribusi dalam produksi energi terbarukan dan manfaatnya bagi masa depan.
Konsep Utama
Bakteri sebagai Penghasil Biogas
Bakteri anaerobik memainkan peran kunci dalam produksi biogas. Dalam proses ini, bakteri memecah bahan organik seperti limbah pertanian atau sampah rumah tangga menjadi metana dan karbon dioksida. Metana kemudian dapat digunakan sebagai sumber energi untuk memasak atau menghasilkan listrik. Proses ini tidak hanya membantu mengurangi limbah tetapi juga menyediakan alternatif energi yang ramah lingkungan.
Konsep Utama
Produksi Hidrogen oleh Bakteri
Beberapa jenis bakteri mampu menghasilkan hidrogen melalui proses fermentasi. Hidrogen adalah sumber energi bersih yang dapat digunakan untuk berbagai keperluan, termasuk kendaraan berbahan bakar hidrogen dan pembangkit listrik. Dengan memanfaatkan kemampuan alami bakteri ini, kita bisa mendapatkan sumber hidrogen yang lebih murah dan berkelanjutan dibandingkan metode konvensional.
Saran Praktis
Manfaat Lingkungan dari Energi Berbasis Bakteri
Menggunakan bakteri untuk menghasilkan energi terbarukan memiliki banyak manfaat lingkungan. Proses ini membantu mengurangi emisi gas rumah kaca dengan menggantikan penggunaan bahan bakar fosil. Selain itu, pemanfaatan limbah organik sebagai bahan dasar juga membantu mengurangi jumlah sampah di tempat pembuangan akhir. Dengan demikian, teknologi berbasis bakteri tidak hanya menyediakan solusi energi tetapi juga mendukung keberlanjutan lingkungan.
Saran Praktis
Tantangan dan Peluang di Masa Depan
Meskipun teknologi berbasis bakteri menawarkan banyak keuntungan, tantangan seperti efisiensi produksi dan biaya masih perlu diatasi. Penelitian terus dilakukan untuk meningkatkan efektivitas proses biologis ini agar lebih kompetitif secara ekonomi dibandingkan dengan sumber energi lainnya. Namun demikian, peluang besar menanti jika kita berhasil memanfaatkan potensi penuh dari teknologi ini untuk masa depan yang lebih hijau dan berkelanjutan.